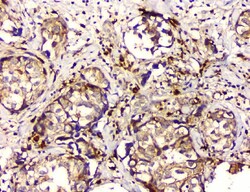
Invitrogen GPX1 Monoclonal Antibody (8B10) 100 &mu;g; Unconjugated:Antibodies,

Learn More
Invitrogen™ GPX1 Monoclonal Antibody (8B10)


Mouse Monoclonal Antibody
Brand: Invitrogen™ MA549180
Description
Adding 0.2 mL of distilled water will yield a concentration of 500 μg/mL. Immunogen sequence is different from the related mouse sequence by six amino acids and from the related rat sequence by five amino acids. Positive Control - WB: human placenta tissue, human U-87 whole cell, human THP-1 whole cell, human U-937 whole cell, human HepG2 whole cell, rat brain tissue, rat thymus tissue, rat lung tissue, rat liver tissue, mouse brain tissue, mouse thymus tissue, mouse lung tissue, mouse liver tissue. IHC: human lung cancer tissue, human mammary cancer tissue. Flow: U87 cell, U251 cell. Store at -20°C for one year from date of receipt. After reconstitution, at 4°C for one month. It can also be aliquotted and stored frozen at -20°C for six months. Avoid repeated freeze-thaw cycles.
Glutathione peroxidases (Gpxs) are ubiquitously expressed proteins which catalyze the reduction of hydrogen peroxides and organic hydroperoxides by glutathione. There are several isoforms which differ in their primary structure and localization. The classical cytosolic/mitochondrial GPx1 (cGPx) is a selenium-dependent enzyme, first of the GPx family to be discovered. GPx2, also known as gastrointestinal GPx (GI-GPx), is an intracellular enzyme expressed only at the epithelium of the gastrointestinal tract. Extracellular plasma GPx (pGPx or GPx3) is mainly expressed by the kidney from where it is released into the blood circulation. Phospholipid hydroperoxide GPx4 (PH-GPx) expressed in most tissues, can reduce many hydroperoxides including hydroperoxides integrated in membranes, hydroperoxy lipids in low density lipoprotein or thymine. All mammalian GPx family members, except for the recently described Cys containing GPx3 and epididymis-specific secretory GPx (eGPx or GPx5) isoforms, possess selenocysteine at the active site.
Specifications
| GPX1 | |
| Monoclonal | |
| 500 μg/mL | |
| PBS with 4mg trehalose and 0.05mg sodium azide | |
| P04041, P07203, P11352 | |
| GPX1 | |
| A synthetic peptide corresponding to a sequence in the middle region of human GPX1 (116-146aa EVNGAGAHPLFAFLREALPAPSDDATALMTD). | |
| 100 μg | |
| Primary | |
| Human, Mouse, Rat | |
| Antibody | |
| IgG2b |
| Flow Cytometry, Immunohistochemistry (Paraffin), Western Blot, Immunocytochemistry | |
| 8B10 | |
| Unconjugated | |
| GPX1 | |
| AI195024; AL033363; Cellular glutathione peroxidase; CGPx; cytosolic glutathione peroxidase; glutathione peroxidase; glutathione peroxidase 1; Gpx; Gpx1; GPx-1; GPXD; GSHPx; GSHPX1; GSHPx-1; HGNC:4553; MGC14399; MGC88245; OTTHUMP00000210766; Selenium-dependent glutathione peroxidase 1 | |
| Mouse | |
| Antigen affinity chromatography | |
| RUO | |
| 14775, 24404, 2876 | |
| -20°C | |
| Lyophilized |
Your input is important to us. Please complete this form to provide feedback related to the content on this product.